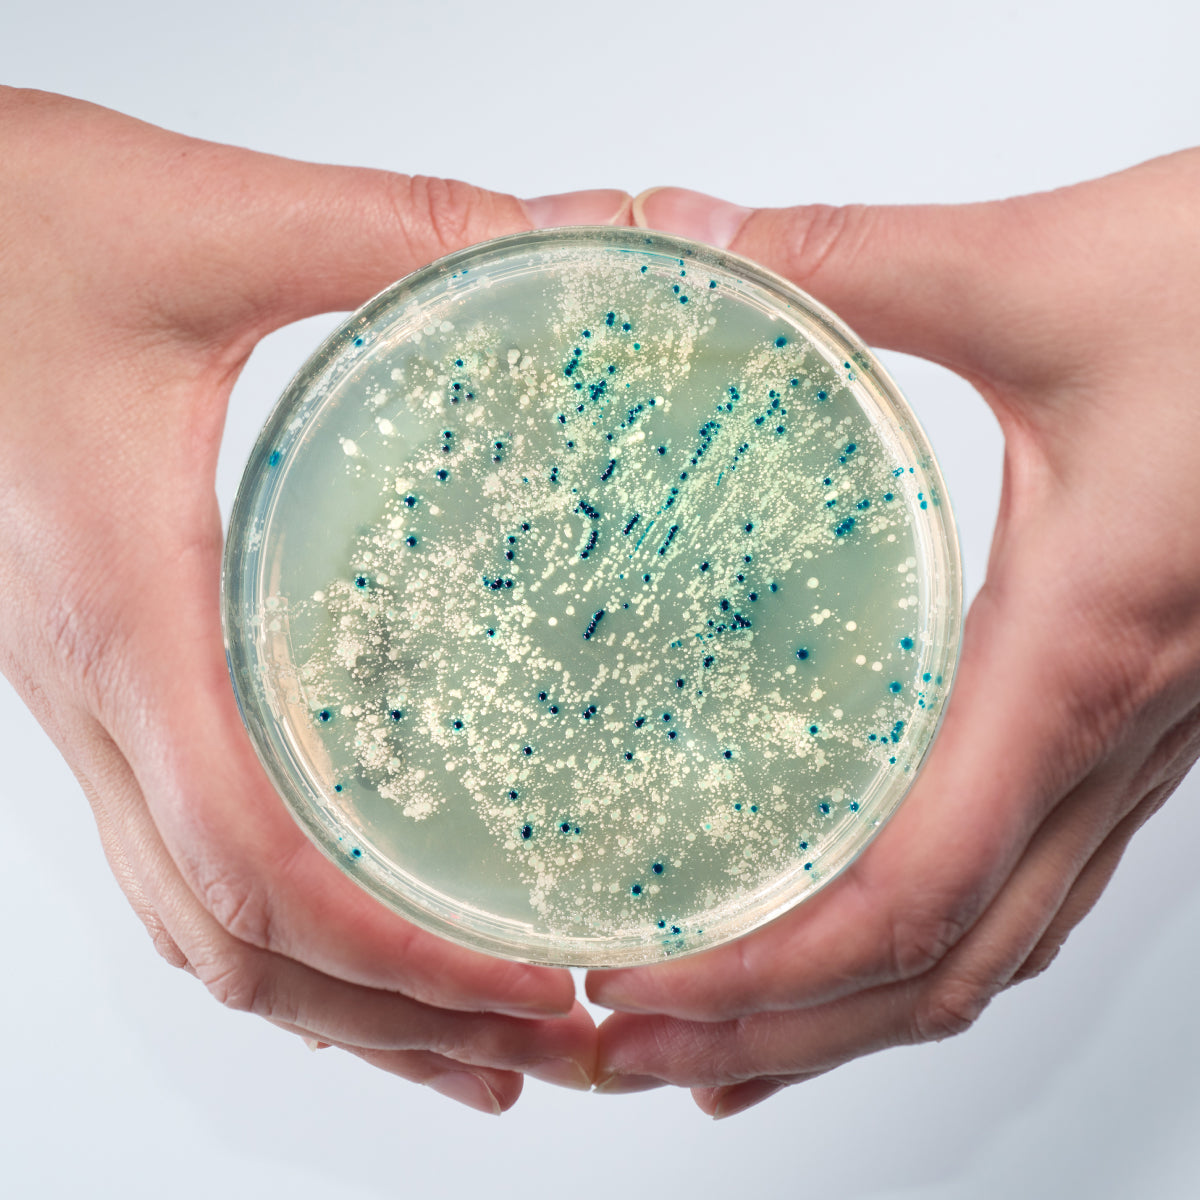

How we make Hypochlorous Acid
Furthering the development of Electro-Chemical Activated (ECA) Technology, Briotech has scientifically engineered a process to mass-produce Hypochlorous products that are highly-effective. The ECA formulations that Briotech produces are superior in purity and have been proven to maintain electrical efficacy beyond known barriers. In this stable form, these electrically active Hypochlorous Acid solutions maintain efficacy and power to influence many biochemical events in human and animal tissues, and in microbes.
Under strict quality-control procedures completed at the precise pH to ensure purity and no hypochlorite (bleach) contamination, we use water (H2O) and salt (NaCl) to create a specific brine solution, and then pass the brine through a proprietary, electrolytic chamber that's unlike any chamber invented. The finished Hypochlorous Acid (HOCl) is a weak acid solution with powerful benefits. This is why Briotech can claim the purity it can and other HOCl manufacturers cannot. Throughout the world, commercial industries such as hospitality, janitorial, food and water processing, agricultural, animal husbandry, and health and public safety have adopted ECA Technology for use, eliminating the need for harmful, toxic chemicals.
10+ years of research
With over a decade of R&D, Briotech has garnered a solid stream of IP and novel techniques that gave way to creation of infinite supplies of high-performing BrioHOCl™.
With these achievements for unlimited production capacity of HOCl that is unmatched in efficacy and shelf life and both pyrogen- and endotoxin-free, Briotech stands alone as a manufacturer of HOCl in its purest form.

How BrioHOCL® is unique
Briotech’s expert record in tightly controlled chemistry of Hypochlorous Acid is evidenced by numerous breakthroughs of its proprietary BrioHOCl™ performed at prestigious institutes and universities, published in a variety of scientific peer-reviewed journals around the world.
Only BrioHOCl™ has been independently tested to eliminate the world’s most dangerous and hardiest pathogen: Prions. Scientists at the NIH-NIAID determined, “…BrioHOCl eliminated all detectable prion-seeding activity for CJD, bovine spongiform encephalopathy (BSE, or mad cow disease), chronic wasting disease (a disease primarily found in deer, elk, and moose) and scrapie...” ¹

How BrioHOCL® is unique
BrioHOCl™ set an industry benchmark for production of Hypochlorous formulations that contain no active components other than pure HOCl and mimic what is produced inside the body more closely than any other HOCl on the market; claims that no other manufacturer can make.
Superior test results of BrioHOCl™ effectiveness against highly resistant, infectious agents (coronavirus, SARS-CoV2, HPV16 & HPV18, human coronavirus OC43, Ebola virus, poliovirus, Staph, and E. coli) are further substantiated by NIH-NIAID's statement: “BrioHOCl had similar [elimination] effects on two proteins thought to contribute to Parkinson’s disease and Alzheimer’s disease.” ¹

INTRODUCING WHISH
Disruptive dispensing Pure Hypochlorous solutions. WHISH® (World HOCl Initiative for Sustainable Health) is an HOCl distributed manufacturing network of geographically dispersed WHISH System that circumvent global supply chain issues by bringing local production of pure Hypochlorous Acid (HOCl) to your part of the world.
Portable, modular WHISH Systems utilize innovative machine-learning IT that’s centrally-controlled and monitored to facilitate unlimited, local production of Hypochlorous Acid using real-time process controls that ensure adherence to pharmaceutical cGMP, EPA, and ISO quality standards.

WHISH SYSTEMS
Features such as continuous-learning driven by algorithms, volumetric monitoring for preventative maintenance, and remote real-time modification for Hypochlorous Acid optimization make Briotech’s WHISH one of the most advanced Hypochlorous Acid production systems to address health, healing, and disinfection within your community.
EXPLORE WHISH